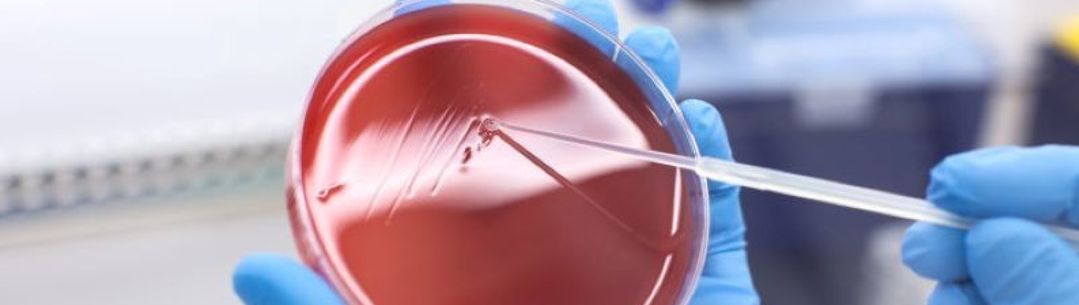

Digital Diagnostics for Africa
Preventable and treatable diseases cause a huge amount of illness and a huge number of deaths in Africa. Not only do these diseases cause major health problems for those infected, they are also a major financial burden to individuals and communities, and they hinder economic and societal development for whole countries. The poorest and most marginalized communities are usually the worst affected, and so these diseases exacerbate inequalities associated with geography, gender and ethnicity.
A multi-disciplinary team bringing together Imperial researchers from Medicine, Engineering and Life Sciences at Imperial are collaborating with the West African Centre for the Cell Biology of Infectious Pathogens (WACCBIP) at University of Ghana to create novel rapid malaria diagnostic linking detection and surveillance.
The Digital Diagnostics for Africa Network brings together 60 members comprised of researchers, commercial partners and not-for-profit organizations, including MRC Gambia Unit at the London School of Hygiene and Tropical Medicine, MinoHealth AI Labs (Ghana), Ghana, Khartoum (Sudan), Makerere (Tanzania), and Sheffield Universities, Institute Pasteur (Senegal), Malaria Consortium, Mologic, GSK, and Gates Foundation.
The research has so far led to the advancement of the underpinning Lacewing technology from proof-of-concept to in-field technology following beta-testing against gold-standard diagnosis of malaria in Ghana. Lacewing is the newest iteration of rapid diagnostic microchip technology developed by Imperial researchers working at the forefront of biomedical electronics.